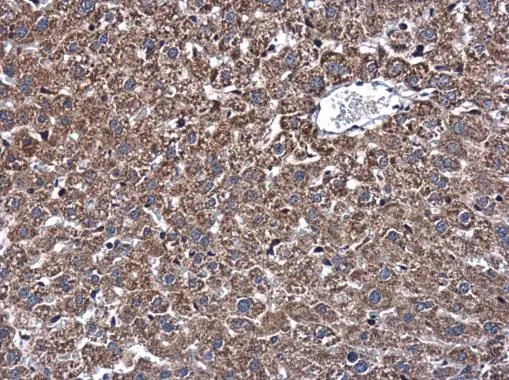
DNAJB11 antibody detects DNAJB11 protein at cytoplasm in mouse liver by immunohistochemical analysis. Sample: Paraffin-embedded mouse liver. DNAJB11 antibody (GTX105619) diluted at 1:500. 
 Antigen Retrieval: Citrate buffer, pH 6.0, 15 min

Immunohistochemistry of paraffin-embedded Rat testis using DNAJB11 Polyclonal Antibody at dilution of 1:100 (40x lens).
DNAJB11 Polyclonal Antibody
E-AB-64376
Product group Antibodies
Overview
- SupplierElabscience
- Product NameDNAJB11 Polyclonal Antibody
- Delivery Days Customer12
- CertificationResearch Use Only
- Scientific DescriptionThis gene encodes a soluble glycoprotein of the endoplasmic reticulum (ER) lumen that functions as a co-chaperone of binding immunoglobulin protein, a 70 kilodalton heat shock protein chaperone required for the proper folding and assembly of proteins in the ER. The encoded protein contains a highly conserved J domain of about 70 amino acids with a characteristic His-Pro-Asp (HPD) motif and may regulate the activity of binding immunoglobulin protein by stimulating ATPase activity.
- UNSPSC12352203